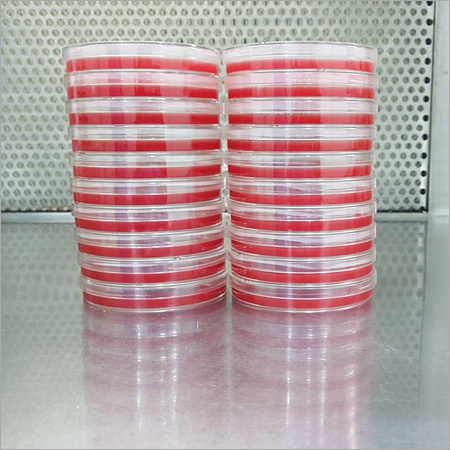
MacConkey Agar Plate

Ready To Use Media Plates By Esvee Biologicals
Price: 800.00 INR / Pack
(800.00 INR + 0% GST)
Get Latest Price
Minimum Pack Size :
80
In Stock
Product Specifications
| Color | light yello |
| Usage | Identification and enumeration of microorganism |
| Size | 90 |
| Product Type | Ready to use culture media plates |
| FOB Port | Mumbai |
| Payment Terms | Cash Advance (CA) |
| Supply Ability | 1000 Per Day |
| Delivery Time | 7 Days |
| Sample Available | Yes |
| Sample Policy | Free samples are available |
| Packaging Details | individual pack |
| Main Export Market(s) | Middle East, Asia, Africa |
| Main Domestic Market | All India |
| Certifications | ISO 9001: 2015 |
| Brand Name | ESVEE BIOLOGICALS |
| Currency | INR |
| Price | 800.00 INR (Approx.) |
| Color | light yello |
| Stock Quantity | 400 |
| Unit Type | Piece/Pieces |
| Product Unit | 80 Piece/Pieces |
| Price Type | fixed |
| Moq | 80 |
| Mop | 80 |
| Returnable | No |
| Minimum Order Quantity | 80 |
| Minimum Ordered Packs | 80 |
| GSTIN | 0% |
Product Overview
Key Features
Company Details
Focusing on a customer-centric approach, ESVEE BIOLOGICALS has a pan-India presence and caters to a huge consumer base throughout the country. Buy Laboratory Glassware & Equipment in bulk from ESVEE BIOLOGICALS at Trade India quality-assured products.
Business Type
Exporter, Manufacturer, Supplier, Trading Company
Employee Count
10
Establishment
2020
Working Days
Monday To Saturday
GST NO
27AHRPL7346N1ZF
Related Products
Explore Related Categories
More Product From This seller
Seller Details
GST - 27AHRPL7346N1ZF
Navi Mumbai, Maharashtra
Business Head
Mr Swapnil Lad
Members since
5 Years
Address
B-106, Silver Springs, Plot No. G-6, M.I.D.C., Taloja, Navi Mumbai, Maharashtra, 410208, India
agar plate in Navi Mumbai
Report incorrect details